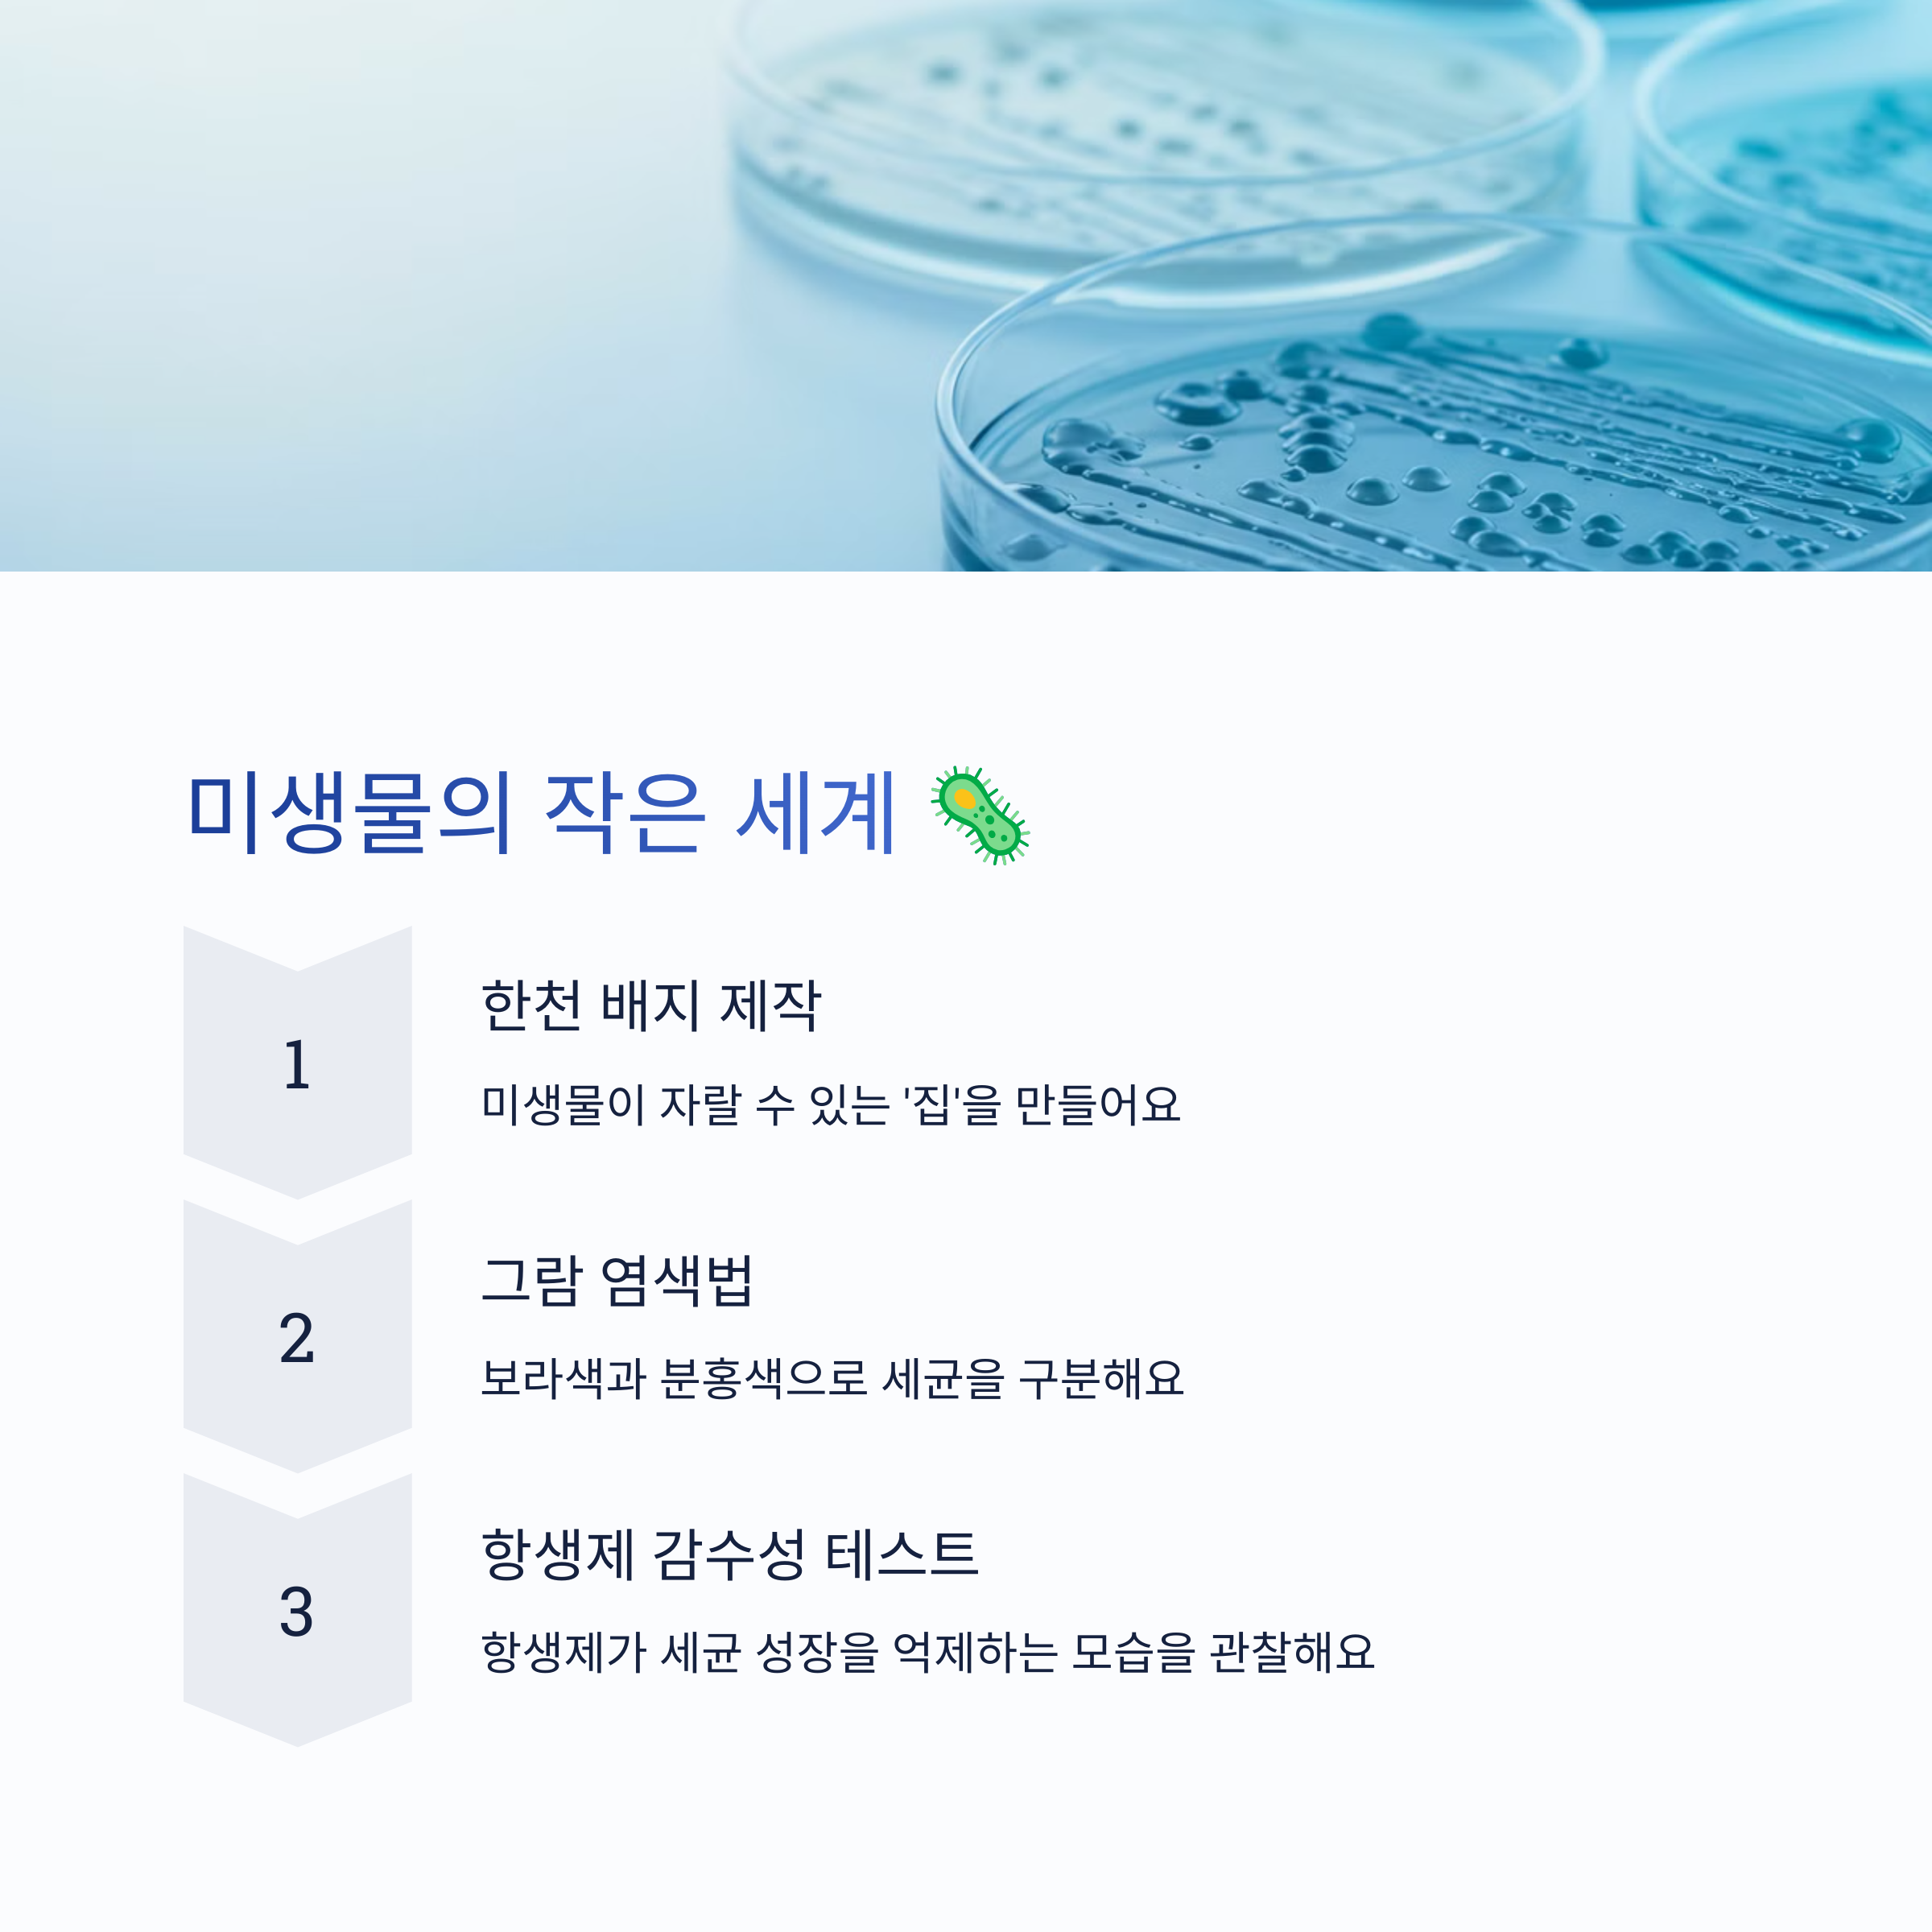
미생물 배양 및 관찰 실험
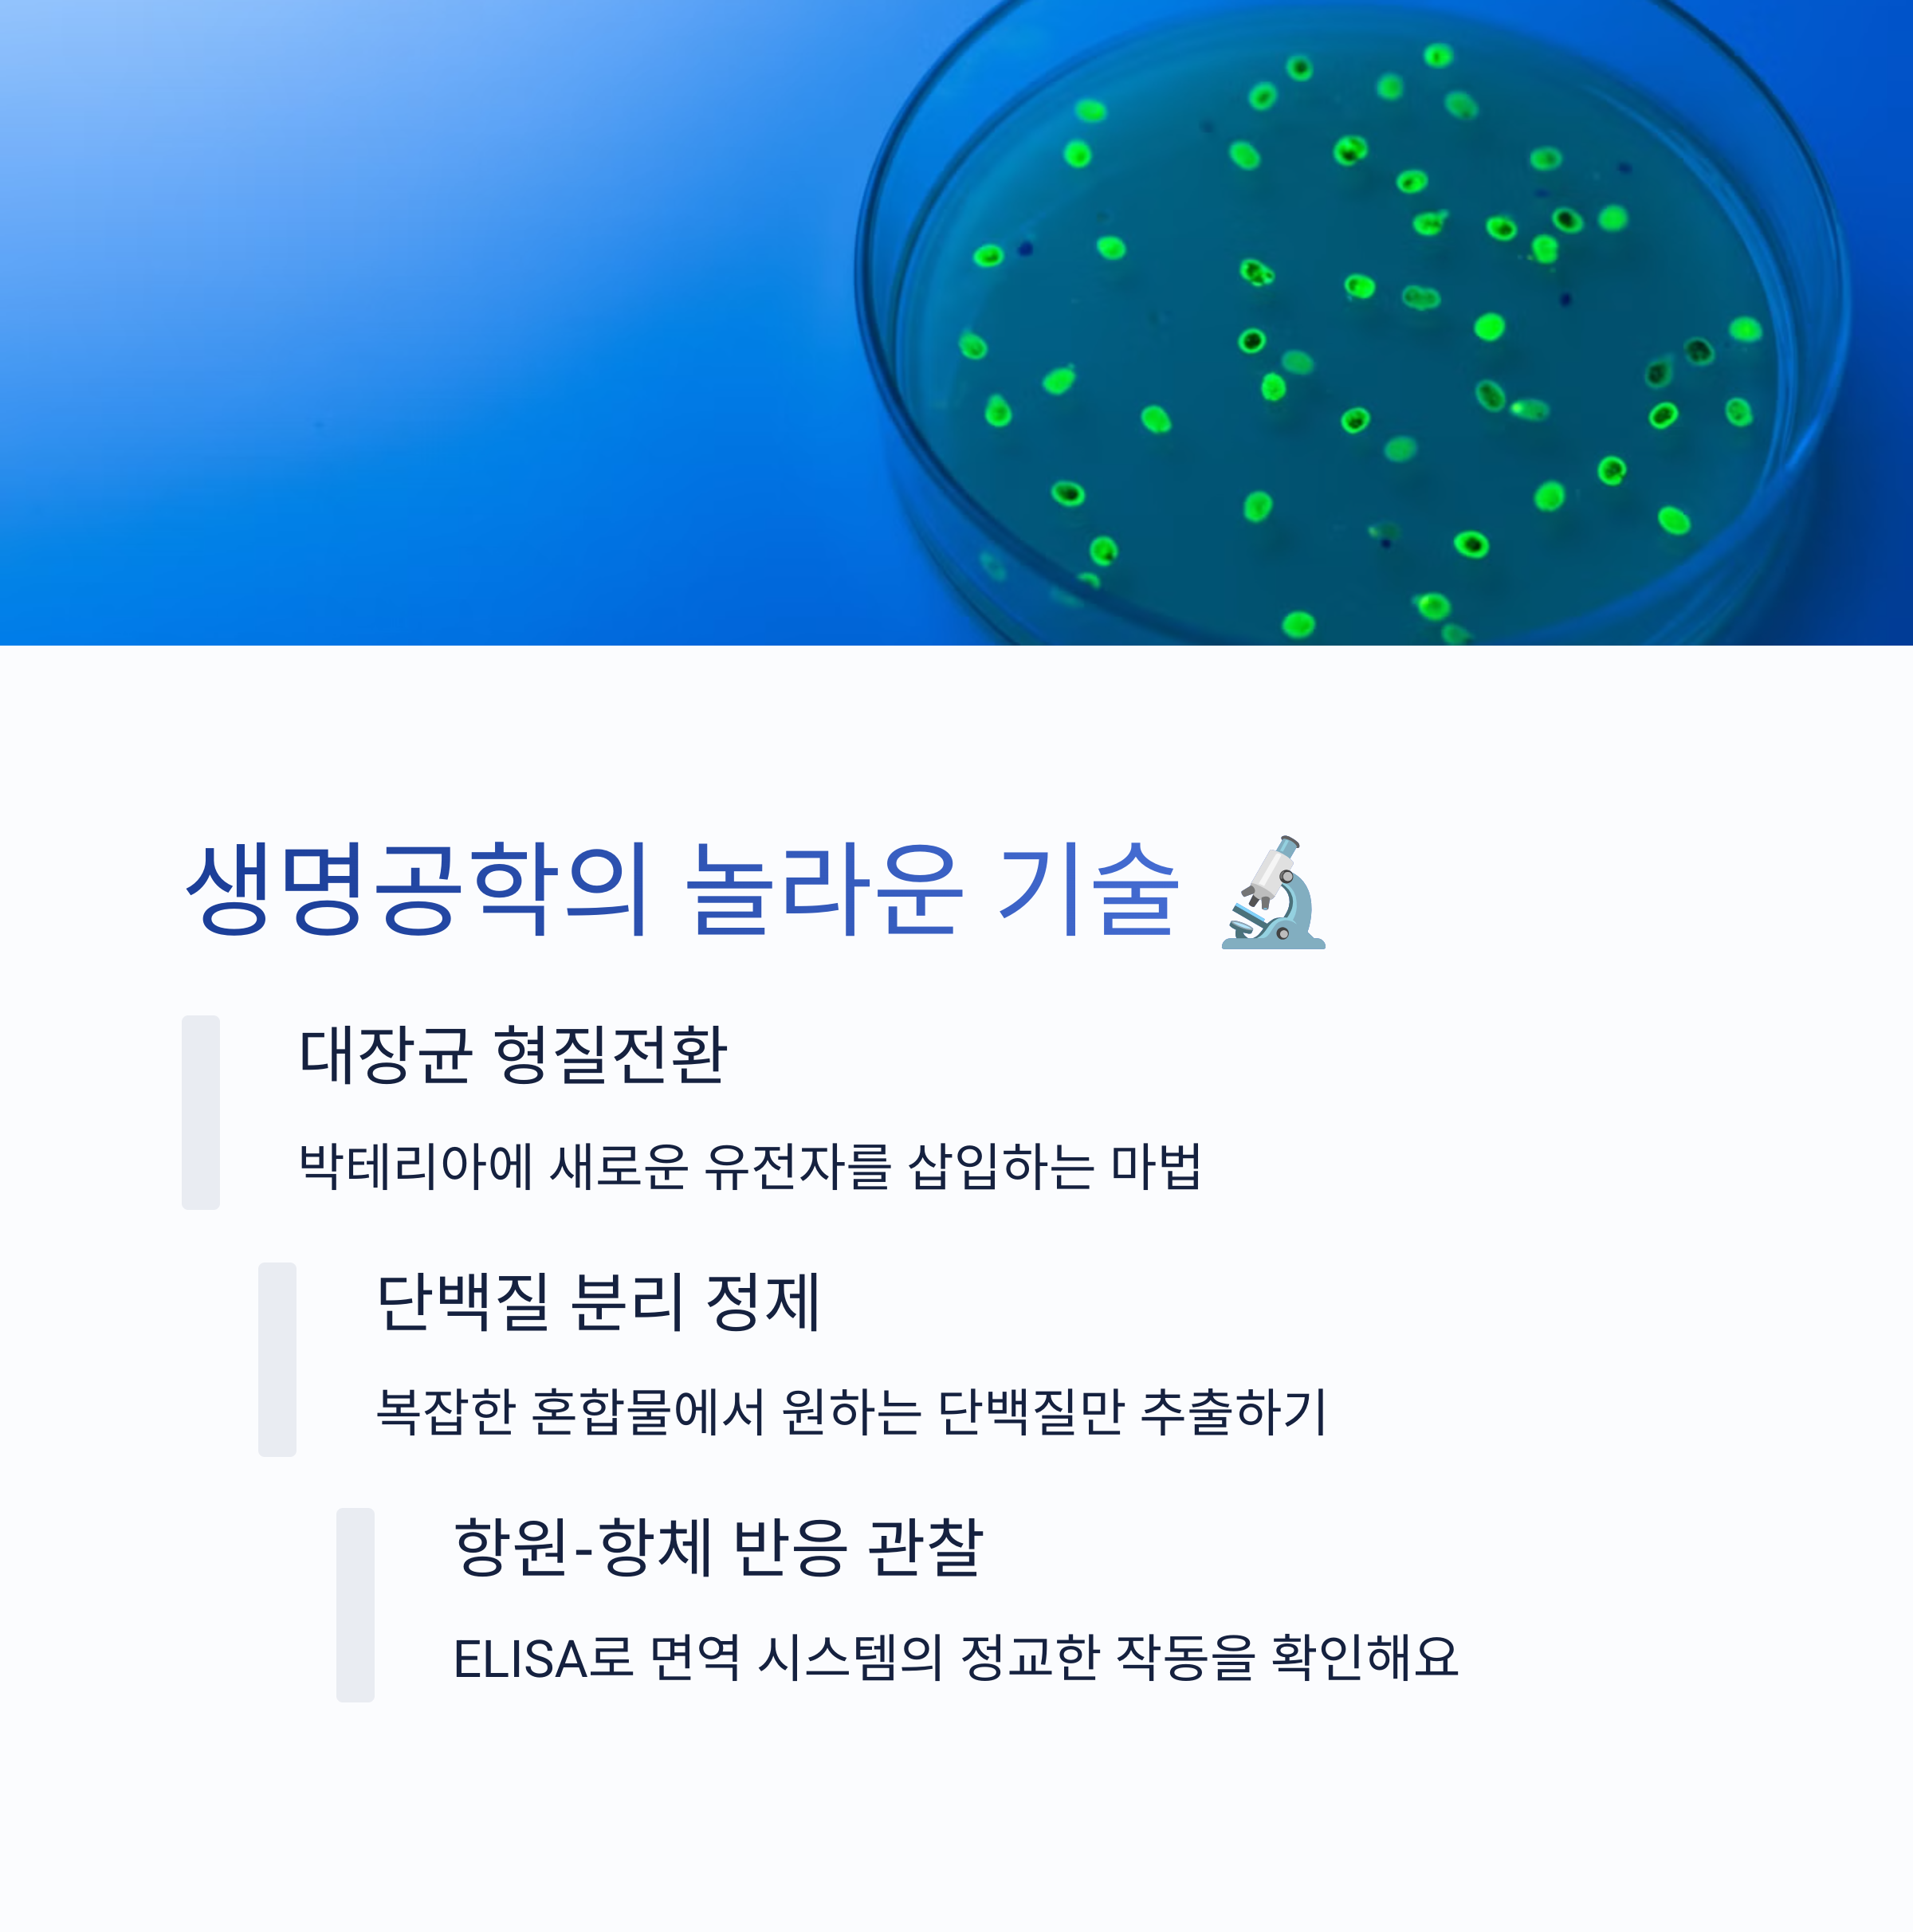

티스토리 뷰
📋 목차

생명과학은 우리 주변의 생명체와 자연을 연구하는 흥미로운 학문이에요! 🌱 다양한 실험을 통해 생명과학의 원리를 직접 체험하면 더욱 깊이 있는 학습이 가능하죠. 🔬
이번 글에서는 고등학교 수준에서 진행할 수 있는 다양한 생명과학 실험들을 추천해 드릴게요! 기본 개념을 이해하는 실험부터 최신 생명공학을 활용한 실험까지 다양하게 정리했어요. 😃
기초 생명과학 실험 🏫
먼저, 생명과학을 처음 접하는 학생들에게 적합한 기본적인 실험부터 살펴볼게요. 🔬 이 실험들은 생명과학의 핵심 개념을 쉽게 이해할 수 있도록 도와줘요!
📌 기초 생명과학 실험 추천
| 실험 제목 | 설명 | 필요한 재료 |
|---|---|---|
| 세포 관찰 실험 | 양파 세포와 사람 뺨 세포를 현미경으로 관찰하여 세포 구조를 비교해요. | 현미경, 양파, 면봉, 메틸렌 블루 염색액 |
| 삼투압 실험 | 소금물과 증류수를 이용해 감자나 양파의 삼투 현상을 확인해요. | 감자, 소금, 증류수, 유리컵 |
| 효소 작용 실험 | 과산화수소와 감자를 이용하여 카탈라아제 효소 반응을 관찰해요. | 감자, 과산화수소, 시험관 |
| 혈액형 판별 실험 | 모의 혈액과 항원-항체 반응을 이용해 혈액형을 확인해요. | 모의 혈액 키트, 혈액형 항체 시약 |
위의 실험들은 비교적 간단하면서도 생명과학의 기본 개념을 이해하는 데 큰 도움이 돼요! 🔬
이제 좀 더 심화된 생명과학 실험을 알아볼까요?
DNA와 유전자 관련 실험 🧬

유전자는 생명의 기본 단위예요! 🧬 DNA를 직접 추출하거나, 유전자 발현을 확인하는 실험을 통해 생명과학의 신비로운 세계를 경험해 볼 수 있어요.
🧪 DNA 관련 실험 추천
| 실험 제목 | 설명 | 필요한 재료 |
|---|---|---|
| 딸기 DNA 추출 | 딸기의 DNA를 직접 추출하여 눈으로 관찰해요. | 딸기, 세제, 소금, 에탄올, 필터 |
| 파파야 DNA 분해 실험 | 파파야의 효소가 DNA를 분해하는 과정을 관찰해요. | 파파야, DNA 용액, 시험관 |
| PCR 유전자 증폭 | DNA를 복제하여 특정 유전자를 증폭하는 과정을 실험해요. | PCR 장비, 프라이머, DNA 샘플 |
| 유전자 전기영동 | 전기영동을 이용해 DNA 조각의 크기를 분석해요. | 아가로스 젤, 전기영동 장치, DNA 시료 |
이 실험들은 생명공학 분야에서도 많이 활용되는 기술이에요. 특히 PCR과 전기영동은 실험실에서 필수적인 기법이죠! 🔬
광합성과 세포 호흡 실험 🌿

식물은 빛을 이용해 에너지를 만들고(광합성), 세포는 산소를 이용해 에너지를 소비하는 과정(세포 호흡)을 거쳐요. 🌞 이 과정을 직접 실험하면 생명과학 개념을 더욱 쉽게 이해할 수 있어요!
🔬 광합성과 세포 호흡 실험 추천
| 실험 제목 | 설명 | 필요한 재료 |
|---|---|---|
| 광합성 산소 발생 실험 | 수중 식물(엘로데아)을 이용해 빛에 따라 산소 방울이 생성되는지를 확인해요. | 엘로데아, 비커, 물, 조명 |
| 잎의 녹말 확인 실험 | 광합성 결과물인 녹말을 요오드 용액으로 확인해요. | 잎, 알코올, 요오드 용액 |
| 이산화탄소 흡수 실험 | BTB 용액을 이용해 식물이 CO₂를 흡수하는 것을 관찰해요. | BTB 용액, 식물, 비커 |
| 효모의 세포 호흡 실험 | 효모가 포도당을 분해하여 이산화탄소를 생성하는 과정을 확인해요. | 효모, 설탕, 물, 시험관 |
광합성은 빛이 필수적이며, 세포 호흡은 산소가 필요하다는 사실을 직접 실험을 통해 확인할 수 있어요! 🌱
미생물 배양 및 관찰 실험 🦠
미생물은 우리 눈에는 보이지 않지만, 자연과 인체에서 중요한 역할을 해요. 🦠 직접 미생물을 배양하고 관찰하는 실험을 통해 생명과학의 미세한 세계를 경험해 볼 수 있어요!
🔬 미생물 실험 추천
| 실험 제목 | 설명 | 필요한 재료 |
|---|---|---|
| 손 씻기 효과 실험 | 손을 씻기 전후의 세균을 배양하여 위생의 중요성을 확인해요. | 페트리 접시, 배지, 면봉 |
| 우유 산균 배양 | 요거트를 만들면서 젖산균의 증식을 관찰해요. | 우유, 요거트, 따뜻한 장소 |
| 빵 곰팡이 배양 | 곰팡이가 자라는 조건을 비교하며 생장 환경을 연구해요. | 빵, 밀폐 용기, 물 |
| 항생제 효과 실험 | 다양한 항생제나 소독제가 박테리아에 미치는 영향을 실험해요. | 페트리 접시, 배지, 항생제 시약 |
미생물 실험은 멸균과 위생 관리가 중요해요! 실험 후에는 반드시 손을 깨끗이 씻고 도구를 소독해야 해요. 🧼
생명공학과 응용 실험 🔬
생명공학은 DNA 조작, 세포 배양, 유전자 변형 등을 연구하는 분야예요. 🔬 실생활에서 활용되는 생명공학 실험을 통해 현대 과학 기술이 어떻게 응용되는지 배울 수 있어요.
🚀 생명공학 실험 추천
| 실험 제목 | 설명 | 필요한 재료 |
|---|---|---|
| 형광 단백질 발현 실험 | 유전자 재조합 기술을 이용해 형광 단백질을 발현해요. | 재조합 DNA 키트, 형광 단백질 |
| 세포 배양 실험 | 세포를 배양하여 생장과 분열 과정을 관찰해요. | 세포 배양 키트, 배지 |
| 효소 활성 측정 | 온도와 pH에 따른 효소의 활성 변화를 실험해요. | 아밀라아제, 전분 용액 |
| GMO 식품 확인 실험 | GMO(유전자 변형 생물) 식품을 PCR로 분석해요. | PCR 키트, GMO 샘플 |
생명공학 실험은 실생활에서도 활용되는 기술이 많아요! 유전자 분석, 질병 치료 등 여러 분야에서 중요한 역할을 하죠. 🧬
환경과 생태 관련 실험 🌎

생태계와 환경 변화는 우리 생활과 밀접한 관계가 있어요. 🌱 다양한 실험을 통해 자연의 순환과 환경 보호의 중요성을 직접 경험해 볼 수 있어요!
🌍 환경과 생태 실험 추천
| 실험 제목 | 설명 | 필요한 재료 |
|---|---|---|
| 탄소 배출과 온실 효과 | CO₂ 농도 증가에 따른 온실 효과 변화를 실험해요. | 페트병, 촛불, 이산화탄소 발생 장치 |
| 수질 오염 실험 | 다양한 물 샘플을 비교하여 오염 정도를 분석해요. | 물 샘플, pH 시험지, 탁도 측정기 |
| 미세먼지 측정 실험 | 공기 중 미세먼지를 채집하고 분석해요. | 투명 필터지, 현미경 |
| 토양 생태계 실험 | 토양 속 미생물과 분해 작용을 관찰해요. | 흙, 분해 가능한 물질(나뭇잎 등) |
환경과 생태 실험을 통해 자연 보호의 중요성을 직접 체험할 수 있어요. 💚 작은 실천이 환경을 지키는 큰 힘이 될 수 있답니다!
FAQ ❓

Q1. 집에서도 할 수 있는 간단한 생명과학 실험이 있나요?
A1. 네! 딸기 DNA 추출, 빵 곰팡이 배양, 효소 반응 실험(감자와 과산화수소) 등은 집에서도 쉽게 할 수 있는 실험이에요. 🏠
Q2. 생명과학 실험을 할 때 주의해야 할 점은?
A2. 안전이 최우선이에요! 실험 중 화학물질을 다룰 때는 장갑과 보호경을 착용하고, 실험 후에는 손을 깨끗이 씻어야 해요. 🧤
Q3. 학교에서 진행하기 좋은 생명과학 실험은?
A3. 광합성 산소 발생 실험, 미생물 배양 실험, 혈액형 판별 실험 등이 학교에서 진행하기 좋아요. 🔬
Q4. 생명과학 실험을 정리할 때 중요한 포인트는?
A4. 실험 목표, 과정, 결과 분석, 결론을 명확히 정리하는 것이 중요해요. 그래프와 표를 활용하면 더 효과적이에요. 📊
Q5. 실험 기구가 없을 때 대체할 방법이 있을까요?
A5. 네! 현미경이 없으면 스마트폰 카메라 + 돋보기를 활용하고, 실험 배지는 젤라틴을 이용해 대체할 수 있어요. 📱🔍
Q6. 생명과학 실험 결과가 예상과 다르게 나왔어요. 왜 그런 걸까요?
A6. 환경 요인(온도, 습도), 실험 과정에서의 오차, 시약 상태 등이 원인이 될 수 있어요. 실험을 반복해서 확인해 보는 것이 좋아요. 🔄
Q7. 생명과학 실험 보고서를 잘 쓰는 팁이 있나요?
A7. 실험 과정과 결과를 논리적으로 정리하고, 결과에 대한 해석과 결론을 명확하게 작성하는 것이 중요해요. 📖
Q8. 대학 입시에서 도움이 되는 생명과학 실험은?
A8. DNA 추출, PCR 유전자 증폭, 미생물 배양, 효소 반응 실험 등은 연구 프로젝트로 활용할 수 있어요. 🏆
생명과학 실험은 개념을 직접 체험할 수 있는 좋은 기회예요! 🔬 흥미로운 실험을 통해 과학적 사고력을 키워 보세요. 🚀
다양한 생명과학 실험을 직접 해 보고, 환경 보호와 생명공학 기술의 발전에 대한 관심도 키워보길 바라요! 🌍✨
